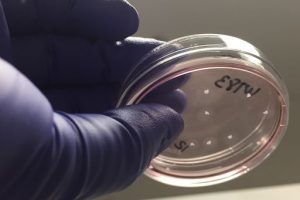
UC-San-Diego-Health-Sciences-Research-300x200.jpeg

Sierra Space is looking to further develop biotech and biopharma R&D in microgravity, working with the University of California San Diego. The space transportation specialist – which is based in Sparks, Nevada – has announced the signing of a new Memorandum of Understanding (MOU) with the Californian university. They are looking to create what they describe as the First Stem ...
Medical Electronics
Content related to medical electronics
Elastomer engineering finally gets deep images from skin patch ultrasound
Engineers at MIT have found a way to get sub-mm resolution and deep penetration from a stick-on ultrasound patch that can be worn for at least two days and peels off at the end of monitoring without leaving residue. In a proof-of-concept, they demonstrated sub-mm resolution images in the first centimetres of tissue, allowing blood vessels to be monitored live, ...
The role of Bluetooth and AI in an artificial pancreas
Wireless technology and machine learning combined in an artificial pancreas help type one diabetics live unimpeded, explains Thomas Søderholm. In 2003, biological physicist Philip Nelson wrote: “At the dawn of the 20th century, it was already clear that, chemically speaking, you and I are not much different from cans of soup. And yet we can do many complex and even ...
A helping hand for robotic arms
A clinical trial for a robotic arm based on neuromorphic computing could increase independence for spinal, neuromuscular injury patients, writes Caroline Hayes. Patients with spinal cord or neuromuscular injuries resulting in limited mobility in their upper body could gain some independence if a trial being conducted at ALYN Hospital in Israel is successful. Small groups of patients at the paediatric ...
Mornsun’s medical power supplies are available on short lead times from Relec
Two medical-certified power supplies by Mornsun have been added to the range available from Relec. The 45W LO45 and 65W LO65 series of ac-dc converters are available on short lead times of 10 – 12 weeks. They are certified to IEC/EN/ES60601 2xMOPP (means of patient protection), and are therefore useful for BF (body floating) medical equipment, such as syringe pumps, ...
3.5inch TFT LCD delivers 1,000cd/m2 for medical and test
Disea is making a 3.5inch TFT LCD which can operate up to 1000cd/m2 brightness. Called ZW-T035SGV-05, it has 640 (RGB) x 480 VGA resolution and and a wide viewing angle of almost a hemisphere: 85 – 85 – 85 – 85°. Operation is over -20 to +70°C and it measures 76.74 x 63.74 x 3.2mm. Active area is 70 x ...
Embedded World: Video Interview – Analog Devices’ Vital Signs Monitoring Solutions
At Embedded World 2022, we caught up with Marcus Greenhill, Sales Director of Digital Healthcare (EMEA) at Analog Devices, as part of our promotional coverage for the event. He covers how ADI’s healthcare solutions are designed to accelerate customers’ time-to-market, and at the same time provide access to clinical-grade data. This enables new business models in the data analytics and ...
TE Connectivity completes acquisition of shielding and sealing specialist, Kemtron
Following the acquisition of Essex-based Kemtron, and its French subsidiary Kemtron Sarl, TE Connectivity adds EMI and RFI shielding, environmental sealing, gaskets and components to its portfolio. Commenting on the acquisition, Nick Jones (pictured), vice president and general manager of TE’s Performance Materials business, said: “Combining TE’s expertise in heat shrink tubing, manufacturing scale and distribution with Kemtron’s . . . ...
Silent 300W PSUs for medical or industrial use
Vox Power has added more voltage options to its medical and industrial VCCS300 fan-less 300W power supplies. Standard outputs are now 12, 15, 24, 28, 36, 48 or 56Vdc, and custom versions between 12 and 58V can be arranged. The 54 x 101 x 40mm (4 x 2 x 1.61 inch) power supplies will run from ac voltages between 85 and ...
The biggest challenge for AI is to make it easy to use
The industry and many markets have embraced big data analytics but this will mean a re-think for chip designers who will need new tools to create competitive solutions. According to Ravi Subramanian, senior vice president and general manager of IC verification solutions, Siemens EDA. AI and software are pushing sensing and electronics to the network edge in order to provide ...
 Electronics Weekly
Electronics Weekly